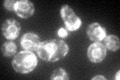
YJL002C
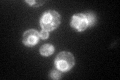
YJL002C

View description
Alpha subunit of the oligosaccharyltransferase complex of the ER lumen, which catalyzes asparagine-linked glycosylation of newly synthesized proteins
Localization:
Intensity:
Fold change:
Significance:
-
C’ GFP library in SD
ER99.2 -
N' NOP1pr-GFP in SD

ER141.884 -
N' TEF2pr-mCherry in SD

ER62.2354 -
N' NATIVEpr-GFP in SD

ER85.7926 -
N' TEF2pr-VC and Cyto-VN in SD

#N/A0 -
C’ GFP library in SD+DTT

ER118.341.19No -
C’ GFP library in SD+H2O2
ER83.970.84No -
C’ GFP library in Starvation Media

ER91.370.92No -
C’ GFP library on the background of Pup2-DaMP

N/A -
C’ GFP library on the background of CCT mutant

N/A0N/AYes
